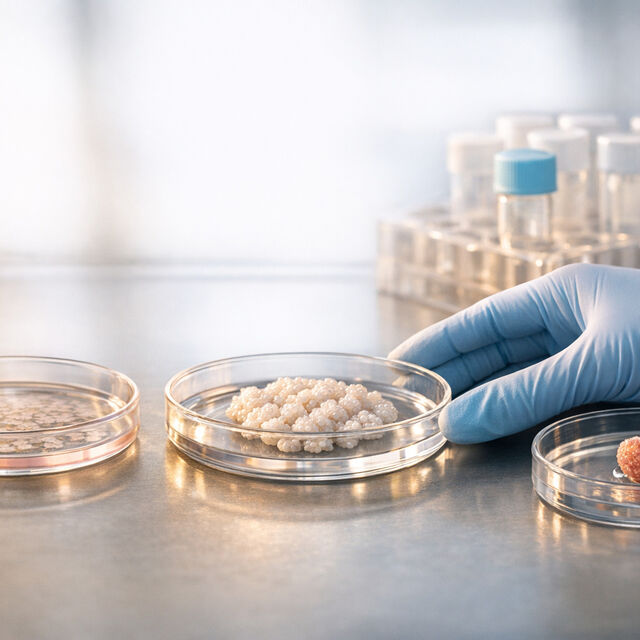
69a8891c12de151ab0272981 1772709529138

How iPSC Therapies Are Changing the Landscape of Cell Treatment
Induced pluripotent stem cells (iPSCs) are reshaping medical science by offering a way to repair or replace damaged tissues with lab-grown cells. Derived from adult skin or blood cells, iPSCs behave like embryonic stem cells but avoid ethical concerns. Here's why this matters:
- Personalized Medicine: iPSCs can be created from a patient’s own cells, reducing rejection risks.
- Disease Treatment: From heart disease to Parkinson's, iPSCs are being tested in over 100 clinical trials worldwide.
- Drug Development: iPSCs provide accurate human models for testing drugs and studying diseases.
- Stem Cell Banking: Preserving newborn stem cells now ensures future access to iPSC-based therapies.
Recent successes include restoring insulin independence in diabetes patients and improving heart function with iPSC-derived patches. While challenges like production costs and safety remain, advances in gene editing, 3D bioprinting, and AI are accelerating progress. Stem cell banking services, such as Americord, are preparing families to benefit from these emerging treatments by preserving cells for decades.
What Are Induced Pluripotent Stem Cells (iPSCs)?
Defining iPSCs
Induced pluripotent stem cells, or iPSCs, are adult cells that scientists have genetically reprogrammed to function like embryonic stem cells. Essentially, these mature cells are reset to an earlier, more flexible state. Unlike embryonic stem cells - which are derived from embryos - iPSCs are created from easily accessible adult tissues like skin or blood cells. This approach avoids the ethical dilemmas tied to embryonic stem cell research while still producing pluripotent cells. In simple terms, being pluripotent means these cells have the ability to develop into almost any cell type in the body.
To contrast, adult stem cells from sources like bone marrow or fat are multipotent, meaning they can only produce specific cell types. iPSCs, however, offer much broader potential, which is why they’ve become a game-changer in stem cell research.
The iPSC Creation Process
The story of iPSCs began in 2006, when Shinya Yamanaka and his team at Kyoto University made a groundbreaking discovery. They identified four critical genes - Oct4, Sox2, Klf4, and c-Myc - that could reprogram mouse skin cells into cells resembling embryonic stem cells. These genes, now known as the "Yamanaka Factors", marked the beginning of a new era in biology. Just a year later, both Yamanaka’s team and James Thomson’s group independently succeeded in creating the first human iPSCs. This achievement earned Yamanaka and John Gurdon the Nobel Prize in Physiology or Medicine in 2012.
Here’s how the process works: scientists introduce the Yamanaka Factors into adult cells, which effectively "erase" their specialized identity and reactivate genes responsible for pluripotency. Early methods relied on viral vectors to deliver these genes, but this posed risks of altering the host’s DNA. Today, safer non-integrating techniques - like Sendai virus, episomal plasmids, or synthetic mRNA - are commonly used. While the efficiency of reprogramming remains low (only about 0.01% to 0.1% of cells successfully convert), the cells that do transform can multiply endlessly in a lab setting.
Medical Benefits of iPSCs
iPSCs tackle two major challenges in regenerative medicine: ethical concerns and immune rejection. Since they can be derived from a patient’s own cells, iPSCs are genetically identical to the individual, reducing the risk of rejection and eliminating the need for long-term immunosuppressant drugs.
"By reprogramming human cells, scientists have created new opportunities to study diseases and develop methods for diagnosis and therapy." – Nobel Prize Judges
Beyond personal treatments, researchers are also developing "super donor" iPSC lines. These are designed to match specific HLA (human leukocyte antigen) matching genes, making them compatible with a broader population. For instance, in Japan, a single well-matched donor line could theoretically benefit 17% of the population without the need for immunosuppression. This potential is already being explored in trials, such as a macular degeneration treatment costing roughly $875,000 per patient. While expensive, these efforts highlight the promise of creating off-the-shelf iPSC donor banks for future therapies.
How iPSC Therapies Are Used in Healthcare
Treating Medical Conditions with iPSC Therapies
As of December 2024, there are 115 clinical trials globally testing 83 human pluripotent stem cell products, with over 1,200 patients treated. These trials are tackling a variety of conditions, including neurological disorders and organ failure.
One of the most promising areas for induced pluripotent stem cell (iPSC) therapies is Parkinson's disease. Between 2018 and 2024, researchers at Kyoto University Hospital conducted a Phase I/II trial involving seven patients aged 50 to 69. These patients received bilateral transplants of iPSC-derived dopaminergic progenitors - cells that produce dopamine, which is deficient in Parkinson's disease. At the 24-month follow-up, PET scans showed a 44.7% increase in dopamine production in the brain's putamen region. Four of the six patients who could be evaluated displayed improved motor function, with an average gain of 9.5 points (20.4%) on the MDS-UPDRS part III OFF score. No serious adverse events or tumor formation were observed.
Heart disease is another focus area. Since 2020, the BioVAT-HF trial at University Medical Center Göttingen has been testing heart muscle patches made from iPSC-derived cardiomyocytes and stromal cells. These patches are surgically placed on damaged heart tissue in patients with advanced heart failure (ejection fraction ≤ 35%). Early results show improved heart contractility in treated areas, though the study is ongoing.
Eye disorders have also seen encouraging results. Between 2019 and 2021, Osaka University treated four patients with severe limbal stem cell deficiency using iPSC-derived corneal epithelial cell sheets. Two years after the procedure, all patients reported sharper vision and reduced corneal cloudiness. In another study involving 18 patients who received retinal pigment epithelium (RPE) cells derived from stem cells, 13 showed increased subretinal pigment, and 10 experienced visual improvements.
In October 2024, a groundbreaking case at Tianjin First Center Hospital in China restored glycemic control in a patient with Type 1 diabetes. Researchers reprogrammed the patient’s adipose-derived mesenchymal stromal cells into chemically induced iPSCs, which were then differentiated into insulin-producing islets and transplanted under the abdominal muscle. After one year, the patient achieved complete insulin independence, with an HbA1c level of about 5%.
These advancements are not only improving treatment options but also reshaping drug development and personalized medicine.
Using iPSCs for Drug Development and Disease Modeling
iPSCs are also revolutionizing how drugs are developed and how diseases are studied. Traditional drug testing often relies on animal models, which don’t always predict human responses accurately. iPSC-derived human cells provide a more reliable way to screen for toxicity and test drug efficacy.
"We make iPSC models from cardiovascular patients' cells, and use them to look at the toxic effects of drugs... and we're close to getting regulators to accept this as an alternative to mouse models, which aren't very predictive at all."
– Christine Mummery, Developmental Biologist, Leiden University
The "disease-in-a-dish" method uses patient-specific iPSCs to create lab-based models of human diseases. By reprogramming cells from patients with conditions like ALS, Alzheimer's, or cancer, researchers can replicate these diseases at the cellular level by harnessing the power of stem cells. This approach allows for deeper exploration of disease mechanisms and testing of treatments without invasive procedures.
iPSC-derived hepatocytes and cardiomyocytes are particularly useful for early-stage drug toxicity testing, identifying harmful side effects before clinical trials begin.
The integration of iPSC technology with CRISPR/Cas9 gene editing has added even more precision. Scientists can now create isogenic cell lines - genetically identical cells that differ only by a specific mutation. This is especially valuable for studying rare diseases, where patient samples are often limited.
Personalized Medicine Through iPSCs
One of the most impactful aspects of iPSC technology is its potential for personalized treatments. Because iPSCs are made from a patient’s own cells - usually from skin or blood - they are a perfect genetic match. This eliminates the risk of immune rejection and reduces the need for immunosuppressant drugs, which often come with serious side effects.
"Patients overwhelmingly favor autologous cell therapies."
– Jarett Anderson and Timothy Nelson, Cell & Gene Therapy Insights
Patient-specific iPSCs also allow for highly tailored drug testing. Treatments can be tested on the patient’s own cells in the lab, providing insights into how they might respond, including potential side effects or variations in effectiveness.
Combining iPSCs with gene-editing tools like CRISPR offers another exciting possibility: correcting genetic mutations before treatment. In this approach, a patient’s cells are reprogrammed into iPSCs, the mutation is fixed, and the corrected cells are then developed into the tissue type needed for transplantation. This could offer a permanent solution for some genetic disorders.
As of late 2021, there were 35 clinical trials using iPSC-derived cells for conditions like heart disease, immune disorders, and Beta-Thalassemia. By the end of 2025, it’s expected that nearly 200 FDA Regenerative Medicine Advanced Therapy (RMAT) designations will be issued. In February 2025, the FDA approved Fertilo for a Phase III clinical trial in the U.S. - the first iPSC-based therapy for reproductive health, using ovarian stem cells to address fertility issues. In April 2025, FT819, an iPSC-derived CAR T-cell therapy for severe Systemic Lupus Erythematosus, received FDA RMAT designation, marking a major step forward in scalable immune treatments.
Newborn Stem Cell Banking and Future Medical Options
Why Stem Cell Banking Matters for Regenerative Medicine
Preserving stem cells at birth ensures they are stored in their optimal state, ready for potential use in future therapies, such as induced pluripotent stem cell (iPSC) treatments, once they become widely available.
Currently, about 3% of U.S. families choose to bank their baby's stem cells, leading to over 100,000 collections annually. This proactive step can prepare families for advancements in medical treatments. For instance, in 2019, Olivia experienced a significant reduction in her ASD symptoms after a quick 15-minute infusion of her own banked cord blood. Similarly, in 2020, Eli received life-changing treatment for Sickle Cell Disease using stem cells preserved from his brother Gus.
"In a private bank setting, starting material can be used to generate personalized, donor-specific iPSCs for autologous use."
– Katherine S Brown, Scientific and Medical Affairs, Cbr Systems Inc.
Banked newborn cells are uniquely suited to create donor-specific iPSCs, which can be developed into any cell type for personalized treatments. This approach eliminates the risk of immune rejection. Americord's innovative 5-compartment vials allow for up to five separate therapies from a single collection, maximizing the potential uses of stored cells.
These advancements are paving the way for cutting-edge storage solutions that align with the future of iPSC-based medical treatments.
How Americord Registry Supports Future iPSC Applications
Americord is committed to preserving stem cells for decades, ensuring families can access emerging iPSC therapies as they progress from experimental stages to routine medical care.
With its Lifetime Storage (78 years) option, Americord guarantees long-term access to stored biological material, accounting for the time it often takes for new therapies to move through clinical trials and regulatory approvals. This extended storage period is crucial for keeping options open as medical science evolves.
The company’s CryoMaxx™ Processing technology preserves cord tissue in its entirety, maintaining all essential cell types - mesenchymal, endothelial, and epithelial - that are vital for regenerative medicine. Additionally, Americord is the only private bank in the U.S. offering Exosome banking for both mother and baby, further expanding possibilities for future research and treatments.
To provide peace of mind, Americord includes a $110,000 Quality Guarantee, ensuring the viability of stored cells. Families can opt for prepaid 20-year or Lifetime (78-year) storage plans, locking in costs and avoiding annual fees. The Lifetime Storage plan ensures that families have the longest possible access to their cells, allowing them to benefit from future medical breakthroughs without worrying about plan expiration.
What's Next for iPSC-Derived Cell Therapies
New iPSC Technologies in Development
Researchers are making strides in iPSC (induced pluripotent stem cell) technologies, combining them with tools like CRISPR gene editing and artificial intelligence to push the boundaries of treatment possibilities. For instance, Century Therapeutics is using CRISPR to engineer immune cells that are "cloaked" by knocking out HLA molecules and overexpressing HLA-E. This clever modification allows transplanted cells to sidestep the patient’s immune system, eliminating the need for heavy immunosuppression. The result? Off-the-shelf therapies that don’t require the time-consuming process of creating patient-specific cells.
In December 2025, a team led by Hongkui Deng at Peking University introduced a serum-free system capable of generating hundreds of iPSC colonies from just 50–100 μL of blood - a volume as small as a fingerstick. Remarkably, this process takes only 18 days and avoids fetal bovine serum, a move that supports clinical applications. These iPSCs were successfully turned into functional pancreatic islets, offering hope for diabetes treatment.
Meanwhile, advancements like 3D bioprinting and innovative delivery methods are reshaping how therapies are applied. At University Medical Center Göttingen, the BioVAT-HF trial utilized epicardial patches loaded with iPSC-derived cardiomyocytes embedded in a collagen matrix. Patients experienced improved heart function, even moving from Stage III to Stage II in the NYHA heart failure classification. Over at UC Davis, fetal surgeon Diana Farmer led the CuRE trial in February 2026, treating six fetuses with spina bifida by applying placenta-derived stem cells directly to their exposed spinal cords. The results were groundbreaking - all newborns showed a reversal of hindbrain herniation, a severe complication of the condition.
Artificial intelligence is also playing a pivotal role in refining manufacturing processes. AI and machine learning are being used to automate quality control, predict differentiation outcomes, and classify colony morphology. These advancements are helping to standardize production, minimize variability, and scale up therapies from research to clinical use.
Challenges in Making iPSC Therapies More Accessible
While these breakthroughs are promising, there are still significant hurdles to overcome before iPSC therapies can be widely accessible. One of the biggest challenges is scaling up manufacturing. Producing enough functional cells for a single patient can require anywhere from 1 million to 100 billion cells. Moving from manual lab processes to automated, closed-system bioreactors is critical to meeting this demand while keeping costs manageable.
Safety remains another concern. Undifferentiated iPSCs can lead to teratomas, so ultrasensitive detection and purification protocols are essential - though these add to production costs. Additionally, iPSC-derived cells can sometimes exhibit a "fetal-like" state rather than mature functionality, which can cause complications like engraftment arrhythmias in cardiac treatments.
The choice between autologous (patient-specific) and allogeneic (universal donor) therapies also presents a dilemma. Autologous therapies avoid immune rejection but are slow and expensive to produce for each individual. On the other hand, allogeneic therapies, while faster and more cost-effective, often require complex immune engineering or HLA-matching to prevent rejection.
Global regulatory inconsistencies further complicate the path to market. Standards for potency assays, release testing, and long-term safety monitoring vary widely, creating roadblocks for efficient approval. Addressing these challenges will require innovative solutions and global collaboration to establish clear, standardized protocols for iPSC-derived therapies.
Conclusion
iPSC therapies offer a groundbreaking way to replace diseased cells with healthy, functional tissue. By sidestepping the ethical debates tied to embryonic stem cells, this approach opens the door to personalized treatments based on a patient's unique genetic profile.
Recent advancements showcase impressive results, such as restoring insulin production and improving heart function. These successes highlight the growing importance of stem cell banking, which ensures access to high-quality, ready-to-use cells for future regenerative treatments.
Preserving newborn stem cells, like those found in cord blood and tissue, is especially valuable. These cells are young and untouched by years of environmental exposure, making them ideal for reprogramming into iPSCs. Since creating an iPSC line can take weeks or months, having banked cells on hand could eliminate delays if therapy is needed.
With nearly 200 FDA RMAT designations projected by 2025, the field is advancing quickly. While hurdles like manufacturing scale and accessibility remain, the progress is undeniable. Americord Registry offers families comprehensive options for preserving cord blood, cord tissue, and placental tissue, ensuring they’re prepared to benefit from emerging therapies.
Banking your newborn's stem cells today is a forward-thinking choice. It’s a way to secure potential medical options as iPSC therapies continue to develop and expand.
FAQs
When will iPSC therapies be widely available in the U.S.?
iPSC therapies are anticipated to become more accessible across the U.S. after completing rigorous clinical trials and securing regulatory approval. With the first Investigational New Drug (IND) clearance for an iPSC-based treatment expected in February 2025, these therapies could see broader availability within a few years - possibly by 2026 or 2027 - as they advance through clinical and regulatory processes.
What are the biggest safety risks of iPSC treatments?
The biggest safety concern with using induced pluripotent stem cell (iPSC) treatments is the risk of tumor formation. Undifferentiated cells, if not properly managed, can develop into teratomas, a type of tumor. This makes it crucial to ensure that only fully differentiated cells are used in treatments.
Another issue comes from the genetic reprogramming process itself. Some methods can lead to changes in the genome, which might further increase the chances of tumor development. To tackle this, researchers are developing non-integrating techniques that avoid altering the genome. However, ensuring genomic stability and reducing tumor risks remain key priorities for making these treatments safe for clinical use.
How could banked newborn stem cells be used to make iPSCs later?
Banked newborn stem cells, such as those from umbilical cord blood or tissue, can be transformed into induced pluripotent stem cells (iPSCs). What makes iPSCs so remarkable is their ability to develop into virtually any cell type, creating a personalized resource for future medical treatments. This method not only minimizes the risk of immune rejection but also preserves the genetic material collected at birth. The result? A powerful tool for regenerative therapies and disease modeling designed specifically for the individual.
The views, statements, and pricing expressed are deemed reliable as of the published date. Articles may not reflect current pricing, offerings, or recent innovations.